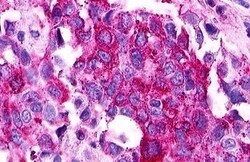
Invitrogen S1P1 Polyclonal Antibody 50 &mu;g; Unconjugated:Antibodies,

missing translation for 'onlineSavingsMsg'
Learn More
Learn More
Invitrogen™ S1P1 Polyclonal Antibody


Rabbit Polyclonal Antibody
Brand: Invitrogen™ PA534181
This item is not returnable.
View return policy
Description
Percent identity with other species by BLAST analysis: Human, Platypus (100%).
S1P1 is a G-protein coupled receptor for the bioactive lysosphingolipid sphingosine 1-phosphate (S1P) that is coupled to the G(i) subclass of heteromeric G proteins. S1P1 signaling leads to the activation of RAC1, SRC, PTK2/FAK1 and MAP kinases. It plays an important role in cell migration via its role in the reorganization of the actin cytoskeleton and formation of lamellipodia in response to stimuli that increase the activity of the sphingosine kinase SPHK1. S1P1 is required for normal chemotaxis toward sphingosine 1-phosphate, normal embryonic heart development, and normal cardiac morphogenesis.
Specifications
| S1P1 | |
| Polyclonal | |
| Unconjugated | |
| S1PR1 | |
| AI849002; CD antigen CD363; CD363; CD363 antigen; CHEDG1; D1S3362; ECGF1; EDG1; EDG-1; EDG1 (Edg1); Edg1; rhodopsin family G protein-coupled receptor; endothelial differentiation G-protein coupled receptor 1; endothelial differentiation sphingolipid G-protein-coupled receptor 1; endothelial differentiation, sphingolipid G-protein-coupled receptor, 1; etID43307.22; Lpb1; Lysophospholipid receptor B1; S1p; S1P receptor 1; S1P receptor Edg-1; s1p1; S1PR1; sphingosine 1-phosphate receptor; sphingosine 1-phosphate receptor 1; sphingosine 1-phosphate receptor EDG1; Sphingosine 1-phosphate receptor Edg-1; sphingosine-1-phosphate receptor 1; wu:fb98f05 | |
| Rabbit | |
| Antigen Affinity Chromatography | |
| RUO | |
| 1901 | |
| Store at 4°C short term. For long term storage, store at -20°C, avoiding freeze/thaw cycles. | |
| Liquid |
| Immunohistochemistry (Paraffin) | |
| 1 mg/mL | |
| PBS with 0.1% sodium azide | |
| P21453 | |
| S1PR1 | |
| Synthetic 16 amino acid peptide from 1st cytoplasmic domain of human S1PR1 / EDG1. | |
| 50 μg | |
| Primary | |
| Human | |
| Antibody | |
| IgG |
Product Content Correction
Your input is important to us. Please complete this form to provide feedback related to the content on this product.
Product Title
Spot an opportunity for improvement?Share a Content Correction